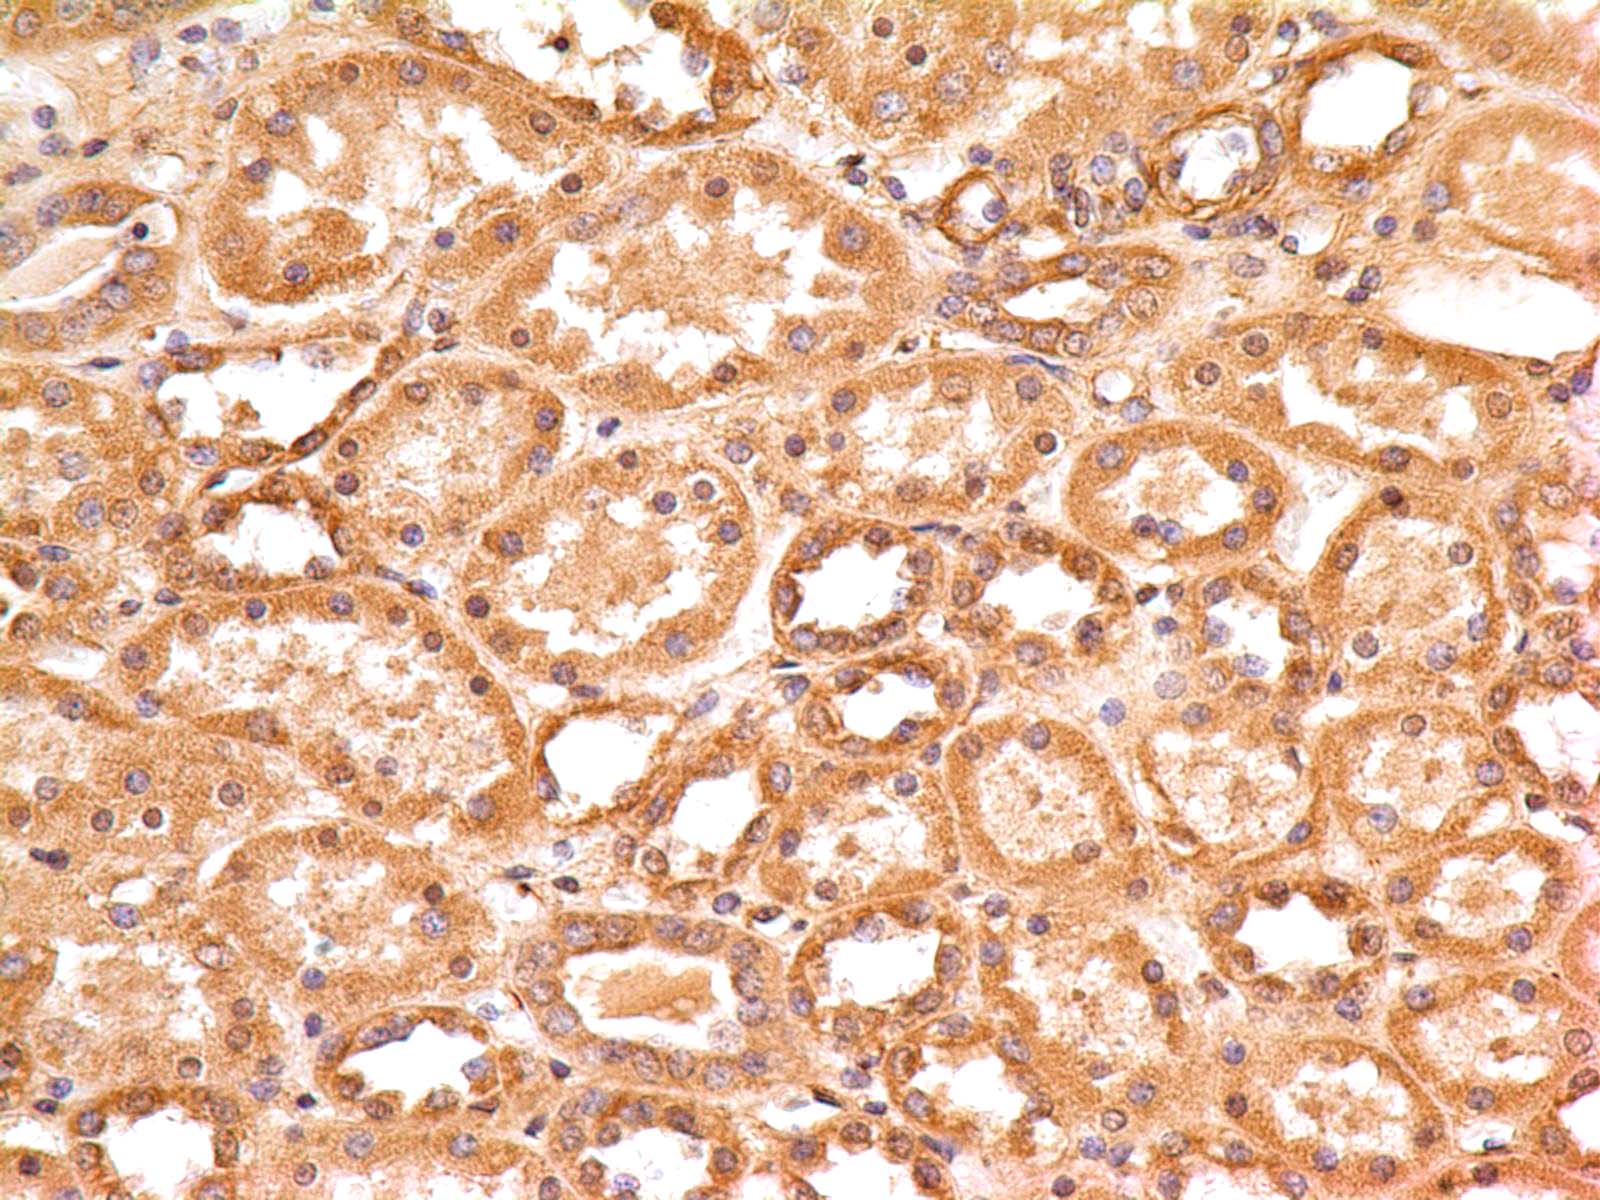

Monoclonal antibody to SLC31A1 (Clone: ABM5D89)
Figure-1: Western blot analysis of SLC31A1. Anti-SLC31A1 antibody (Clone: ABM5D89) was tested at 1 µg/ml on (1) T98G and (2) THP1 lysates.
Roll over image to zoom in
Shipping Info:
Order now and get it on Thursday May 14, 2026
Same day delivery FREE on San Diego area orders placed by 1.00 PM
| Format : | Purified |
| Amount : | 100 µg |
| Isotype : | Mouse IgG2b, Kappa |
| Purification : | Protein G Chromatography |
| Content : | 25 µg in 50 µl/100 µg in 200 µl PBS containing 0.05% BSA and 0.05% sodium azide. Sodium azide is highly toxic. |
| Storage condition : | Store the antibody at 4°C; stable for 6 months. For long-term storage; store at -20°C. Avoid repeated freeze and thaw cycles. |
Recommended dilutions: Western blot analysis: 1-2 µg/ml, Immunohistochemical analysis: 5 µg/ml. However, this need to be optimized based on the research applications.
For Research Use Only. Not for use in diagnostic/therapeutics procedures.
| Subcellular location: | Cell membrane |
| Post transnational modification: | O-Glycosylation at Thr-27 protects from proteolytic cleavage in the N-terminal extracellular domain. |
| BioGrid: | 107712. 14 interactions. |
|
There are currently no product reviews
|

.png)











